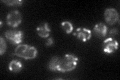

View description
Catabolic L-serine (L-threonine) deaminase, catalyzes the degradation of both L-serine and L-threonine; required to use serine or threonine as the sole nitrogen source, transcriptionally induced by serine and threonine
Localization:
Intensity:
Fold change:
Significance:
-
C’ GFP library in SD

mitochondria119.73 -
N' NOP1pr-GFP in SD

cytosol23.687 -
N' TEF2pr-mCherry in SD

punctateN/A -
N' NATIVEpr-GFP in SD

missing0 -
N' TEF2pr-VC and Cyto-VN in SD

#N/A0 -
C’ GFP library in SD+DTT

mitochondria29.670.24Yes -
C’ GFP library in SD+H2O2

mitochondria125.611.04No -
C’ GFP library in Starvation Media
mitochondria71.920.6Yes -
C’ GFP library on the background of Pup2-DaMP

mitochondria -
C’ GFP library on the background of CCT mutant

mitochondria143.2361.1963No
